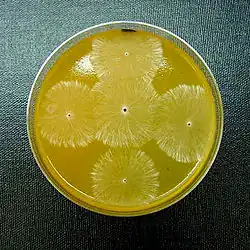

Kolonia (grzyby)
.jpg)
Kolonia – plecha lub grzybnia powstająca w hodowli grzybów na podłożu hodowlanym. Hodowlę taką nazywa się także kulturą. Wiele gatunków grzybów można na hodować w laboratorium na sztucznych podłożach. Zwykle robi się to zaszczepiając grzyba na dobranym podłożu na szalkach Petriego. Hodowla taka jest następnie przetrzymywana w stałej temperaturze w ciemności lub na świetle i systematycznie monitorowana. Ma duże znaczenie przy diagnostyce gatunku grzyba, często umożliwia też poznanie cech jego budowy i rozwoju, które nie są możliwe do zaobserwowania w naturze. Liczne badania z zakresu biologii molekularnej grzybów prowadzi się właśnie w oparciu o ich hodowlę na sztucznych podłożach[1]. Często dany gatunek grzyba w różny sposób rozwija się na różnych podłożach, i to ma znaczenie diagnostyczne przy jego identyfikacji. Posiew grzybów na podłożu hodowlanym i obserwacja rozwoju jego kolonii mają często decydujące znaczenie w laboratoryjnej diagnostyce chorób wywołanych przez grzyby chorobotwórcze[2] i grzybowych chorób roślin wywołanych przez grzyby pasożytnicze[3].
Przy opisie kolonii form drożdżopodobnych uwzględnia się następujące cechy:
- temperatura;
- rodzaj podłoża hodowlanego – często podawany skrótami, np. PDA;
- czas hodowli podawany w dniach[1];
- wielkość kolonii po określonym czasie hodowli – słownie lub przez podanie średnicy w mm;
- konsystencja sprawdzana ezą – sucha, lepka, śluzowata, mazista;
- kształt – okrągły, owalny, nieregularny itp.;
- brzeg – równy, falisty, postrzępiony itp.;
- pionowy rozwój – kolonia płaska, lekko wzniesiona, wypukła, stożkowata itp.;
- kolor – biały, kremowy, beżowy, żółty, barwa podłoża wokół kolonii, strefa przejaśnienia wokół niej itp.;
- przejrzystość – przejrzysta, mętna, opalizująca, nieprzejrzysta;
- zapach – mydlany, kwaśny, piwny, miodowy, gnilny itp.;
- zachowanie w płynie fizjologicznym – łatwo lub trudno tworzy jednolitą zawiesinę, zawiesina jest grudkowata lub niejednorodna[4].
Przy opisie kolonii grzybów strzępkowych (pleśni) uwzględnia się cechy:
- warunki hodowli – temperatura, na świetle lub w ciemności;
- przebieg hodowli – przebiega łatwo, trudno itp.;
- rodzaj podłoża hodowlanego – często podawany skrótami, np. PDA;
- czas hodowli podawany w dniach;
- wielkość kolonii po określonym czasie hodowli – słownie lub przez podanie średnicy w mm[1];
- powierzchnia – wełnista, włóknista, puszysta, zbita, skórzasta itp.;
- wygląd i barwa grzybni – biała, kremowa itp., zmiany barwy w czasie zarodnikowania;
- rewers grzybni – barwa i wygląd dolnej części grzybni przylegającej do szalki Petryego (czasami jest inny niż pozostałej części grzybni);
- kształt – okrągły, owalny, nieregularny itp.;
- strefowanie – niestrefowana lub koncentrycznie strefowana[4];
- struktury tworzone przez grzybnię – konidiomy lub owocniki, chlamydospory, sklerocja, zarodniki itp.;
- zarodnikowanie – obfite, umiarkowane, słabe, brak[1].
Podobnie ocenia się również dolną, przylegającą do szalki Petriego powierzchnię kolonii (rewers)[1].
Przypisy
- 1 2 3 4 5 Joanna Marcinkowska, Oznaczanie rodzajów grzybów sensu lato ważnych w fitopatologii, Warszawa: PWRiL, 2012, s. 10–13, ISBN 978-83-09-01048-7.
- ↑ Fungal culture [online], Leading International Fungal Education, 2011 [dostęp 2023-11-15].
- ↑ Selim Kryczyński, Zbigniew Weber (red.), Fitopatologia. Podstawy fitopatologii, t. 1, Poznań: Powszechne Wydawnictwo Rolnicze i Leśne, 2010, ISBN 978-83-09-01063-0.
- 1 2 Grzyby. Warunki rozwoju grzybów. Morfologia kolonii i komórek drożdży. Morfologia kolonii pleśni. Budowa strzępek zarodnikonośnych [online], Uniwersytet Warmińsko-Mazurski w Olsztynie. Katedra Mikrobiologii Przemysłowej i Żywności, 2011 [dostęp 2023-11-15].